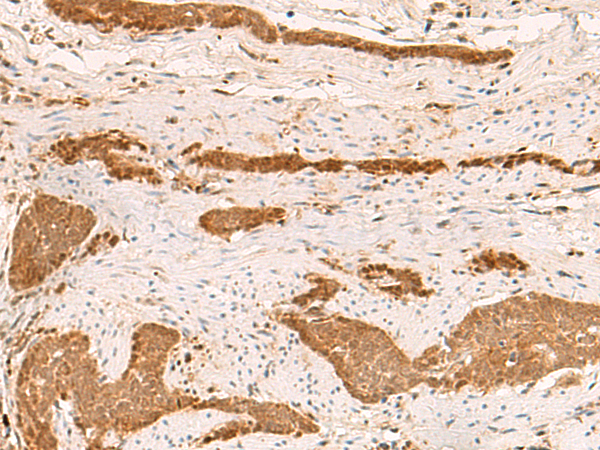

别名:SPG33; PROTRUDIN应用:WB,IHC
反应种属:Human, Mouse, Rat
规格:50μl/100μl
| Description |
|---|
| This gene encodes a protein with several transmembrane domains, a Rab11-binding domain and a lipid-binding FYVE finger domain. The encoded protein appears to promote neurite formation. A mutation in this gene has been reported to be associated with hereditary spastic paraplegia, however the pathogenicity of the mutation, which may simply represent a polymorphism, is unclear. |
| Specification | |
|---|---|
| Aliases | SPG33; PROTRUDIN |
| Swissprot | Q5T4F4 |
| WB Predicted band size | 46 kDa |
| Host/Isotype | Rabbit IgG |
| Storage | Store at 4°C short term. Aliquot and store at -20°C long term. Avoid freeze/thaw cycles. |
| Species Reactivity | Human, Mouse, Rat |
| Immunogen | Fusion protein of human ZFYVE27 |
| Formulation | pH7.4 PBS, 0.05% NaN3, 40% Glycerol |
| Application | |
|---|---|
| WB | 1/500-1/2000 |
| IHC | 1/50-1/300 |
| ELISA | 1/5000-1/10000 |
 |
Gel: 8%SDS-PAGE, Lysate: 40 μg, Lane 1-2: PC3 and Hela cell lysates, Primary antibody: P03105(ZFYVE27 Antibody) at dilution 1/350, Secondary antibody: Goat anti rabbit IgG at 1/5000 dilution, Exposure time: 20 seconds |
 |
The image is immunohistochemistry of paraffin-embedded Human esophagus cancer tissue using P03105(ZFYVE27 Antibody) at dilution 1/50. (Original magnification: ×200) |
|
The image is immunohistochemistry of paraffin-embedded Human liver cancer tissue using P03105(ZFYVE27 Antibody) at dilution 1/50. (Original magnification: ×200) |
本公司的所有产品仅用于科学研究或者工业应用等非医疗目的,不可用于人类或动物的临床诊断或治疗,非药用,非食用。
暂无评论
本公司的所有产品仅用于科学研究或者工业应用等非医疗目的,不可用于人类或动物的临床诊断或治疗,非药用,非食用。
 中文
中文 








发表回复